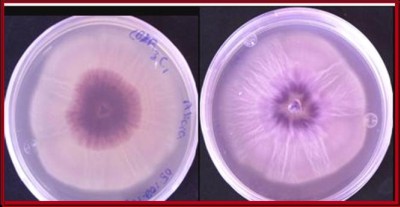

Hasta enero de 2010 el material Puebla presenta el mejor desarrollo
Hasta enero de 2010 el material Puebla presenta el mejor desarrollo
Resultados preliminares del proyecto Validación de cultivares de jamaica con potencial productivo y rentable para las condiciones del sur de Sinaloa indican que de cuatro variedades validadas, hasta enero de 2010 el material Puebla presentaba el mejor desarrollo, con 115 centímetros de altura en planta y 153 cálices por planta. Ver Cuadro 1.
Validación técnica y económica de las variedades de sorgo VC-462 y S-23, con potencial forrajero en áreas de temporal de los municipios de San Ignacio y Elota
{youtube width="600" height="350"}M3BenEb9Cv8{/youtube}
Prevén usar en campo en 2012 producto biológico sinaloense para controlar Fusarium en maíz
 El empleo de microorganismos para combatir la presencia de fusariosis en maíz representa una opción amigable con la naturaleza que no altera ni los suelos ni el entorno de los cultivos
El empleo de microorganismos para combatir la presencia de fusariosis en maíz representa una opción amigable con la naturaleza que no altera ni los suelos ni el entorno de los cultivos
El proyecto Obtención y evaluación de un banco de germoplasma de microorganismos nativos de Sinaloa asociados a maíz para desarrollar bioprotectores para el control de Fusarium prevé iniciar en 2011-2012 la aplicación en maíz en campo de un producto biológico creado con especimenes recolectados de suelos establecidos con este cultivo en nuestro estado, con el objeto de combatir la fusariosis.
El proyecto, que es apoyado por Fundación Produce Sinaloa, A. C., a través de su Consejo Consultivo zona norte, está a cargo del Dr. Ignacio Maldonado, investigador del Centro Interdisciplinario de Investigación para el Desarrollo Integral Regional (CIIDIR)-Sinaloa.
Una solución al empleo desmedido de agroquímicos
Ante el uso excesivo de agroquímicos que ha reducido la biodiversidad de agroecosistemas, causando su inestabilidad y aumentando la contaminación, el aprovechamiento de la diversidad de microorganismos como fuente para combatir enfermedades y plagas es una opción amigable con la naturaleza que no altera ni los suelos ni el entorno de los cultivos.
El objeto del presente proyecto de emplear microorganismos aislados del suelo o ?rizosfera? (?zona biológicamente activa alrededor de las raíces de las plantas, que contiene bacterias y hongos?) asociados al cultivo de maíz es porque así se asegura que éstos estarán mejor adaptados al cultivo, por lo que podrán proveer un mejor control de enfermedades en él; además, como son nativos de Sinaloa estarán adecuados a las condiciones climatológicas y del suelo de nuestro estado, por lo que su eficacia será mayor.
Esquema del proyecto
Esquema del proyecto
Actualmente, en su segunda etapa de desarrollo (de junio de 2009 a mayo de 2010) el proyecto evalúa los 10 mil microorganismos que durante la primera etapa de la investigación (2008-2009) se recolectaron de suelos establecidos con maíz en Sinaloa.
En esta segunda etapa se identifica a nivel molecular a los 10 mil microorganismos para localizar a los posibles antagonistas de Fusarium en maíz. Posteriormente a esta evaluación, para mayo de 2010 se prevé contar con una lista de los especimenes que en ensayos de laboratorio hayan resultado con control sobre el crecimiento del hongo-patógeno.
A partir de junio de 2010 y hasta mayo de 2011 se elaborará un producto biológico (mezcla de microorganismos que hayan inhibido el crecimiento de Fusarium en laboratorio) para aplicarse en maíces de invernadero que presenten síntomas de fusariosis (plantas enanas y con raíces débiles).
Por último, el antagonista o antagonistas que hayan resultado con control sobre fusariosis en invernadero se aplicarán en campo para evaluar resultados.
Suman 2 mil 500 hectáreas de papa con programa de riego vía Internet
 Esperan que el sistema IrriModel V.1.0 permita incrementar en 15% el rendimiento del cultivo de papa en el norte de Sinaloa
Esperan que el sistema IrriModel V.1.0 permita incrementar en 15% el rendimiento del cultivo de papa en el norte de Sinaloa
De octubre de 2009 a enero de 2010, mediante el sistema computacional IrriModel V.1.0, se ha adoptado la programación integral y gestión de riego en tiempo real a través de Internet en casi 2 mil 500 hectáreas de papa en el norte de Sinaloa, según avances de resultados del proyecto Desarrollo y operación de un portal electrónico para la calendarización del riego en tiempo real en papa y consulta agrometeorológica en el norte de Sinaloa.
Reportan a Imagination como mejor híbrido de chile bell
 El material Imagination se coloca a la cabeza en rendimiento y calidad de fruta para exportación en campo abierto en el valle de Culiacán
El material Imagination se coloca a la cabeza en rendimiento y calidad de fruta para exportación en campo abierto en el valle de Culiacán
Avances de resultados de un proyecto apoyado por Fundación Produce Sinaloa, A. C., a través de su Consejo Consultivo zona centro en 2009-2010 indican que en cinco cortes efectuados en un cultivo establecido en campo abierto con 10 materiales de chile bell, los que presentan los mejores rendimientos son Imagination (con 2 mil 359 bultos por hectárea) y Ug-88504 (con 2 mil 323 bultos por hectárea). Ver Figura 1.
La información anterior forma parte de los resultados preliminares del proyecto Evaluación de híbridos de chile bell sobresalientes por calidad, rendimiento, tolerancia a plagas y enfermedades en el valle de Culiacán. Los materiales que se evalúan son Imagination, Revelation, Santiago, Crusade, Sotero, Cardenal, Fs-86, Ug-80504, Grandísimo y Florida Soap, que están establecidos en una parcela del Campo Florencia, Costa Rica, Sinaloa.
También se muestra que hasta enero de 2010 los materiales que ofrecen mayor cantidad de fruta para exportación son Imagination (75% de su rendimiento, es decir mil 783 bultos por hectárea), seguido de Revelation (73% de su rendimiento). Ver Figura 2.
En cuanto a rendimiento de exportación por calibres sobresale el híbrido Ug-80504, con 880 bultos de chile extra grande por hectárea; le sigue Revelation, con 805 bultos de fruta grande por hectárea; e Imagination, con 332 bultos de chile mediano por hectárea. Ver Figura 3.
Monitoreo de plagas y enfermedades
El avance de resultados del proyecto también muestra el monitoreo de las principales plagas que han atacado a los 10 materiales de chile bell evaluados hasta enero de 2010, mes en el que se presentaron hasta cuatro adultos de minador por pulgada cuadrada, 1.5 adultos de mosca blanca por pulgada cuadrada y menos de un adulto de trips por pulgada cuadrada. En el Cuadro 1 se observan los productos empleados para el control de estas plagas.
En cuanto a la presencia de las principales enfermedades del cultivo de chile bell (como son virus mosaico del pepino, virus jaspeado del chile y Clavibacter michiganensis pv. michiganensis) observadas en laboratorio, Revelation fue el único que manifestó virus mosaico del pepino y Clavibacter michiganensis pv. michiganensis, el resto de los materiales sólo presentó virus mosaico del pepino, a excepción de Cardenal (único material que resultó sin problemas). En el campo no se registraron síntomas de enfermedades.
RESULTADOS 2008-2009
Durante 2008-2209, el proyecto Evaluación de híbridos de chile bell sobresalientes por calidad, rendimiento, tolerancia a plagas y enfermedades en el valle de Culiacán validó el comportamiento de los materiales Karisma, Bípode, Yo-5644, Cannon, Valeria, ACX-293, Excursión II, Fiero, Fasinato, MX-5069, Lorca, Zamboni, Monsett y Sympati; los resultados se muestran a continuación.
De los 14 híbridos de chile bell evaluados, los que obtuvieron mejores rendimientos fueron: Cannon, con 5 mil 455 bultos por hectárea (producción de la que el 85% presentó cualidades para exportación); Lorca, con 5 mil 158 bultos por hectárea (de los que el 77% fue apto para exportar); y ACX-293, con 5 mil 46 bultos por hectárea (de los que el 88% presentó características de exportación). El porcentaje de daño por plagas que presentaron estos tres híbridos se observa en el Cuadro 2.
El rendimiento de Cannon, Lorca y ACX-293 se comparó con el obtenido por las variedades que comúnmente utiliza el productor del valle de Culiacán: Zamboni (con 4 mil 651 bultos por hectárea, de los que el 79% fue de exportación) y Monsett (con 4 mil 921 bultos, de los que el 85% presentó características para exportación). El daño presentando por plagas y enfermedades en estos dos materiales se observa en el Cuadro 3.
Con información proporcionada por Ada Ascencio Álvarez, integrante del Instituto Nacional de Investigaciones Forestales, Agrícolas y Pecuarias (INIFAP)

Figura 1. Rendimiento total de los materiales de chile bell validados en el Campo Florencia.

Figura 2. Rendimiento por mercado de los híbridos de chile bell validados en el Campo Florencia.

Figura 3. Rendimiento por calibre de los híbridos de chile bell validados en el Campo Florencia.
Cuadro 1. Productos empleados para el control de enfermedades y plagas.

Cuadro 2. Daño presentado por plagas y enfermedades en híbridos de chile bell que presentaron los mejores rendimientos en casa-sombra.

Reportan aumento de 23% en calidad de leche
 El incremento en la calidad de leche se debe a las buenas prácticas de ordeño que los productores han implementado en sus unidades de producción
El incremento en la calidad de leche se debe a las buenas prácticas de ordeño que los productores han implementado en sus unidades de producción
De acuerdo a resultados preliminares de un proyecto apoyado por Fundación Produce Sinaloa, A. C., a través de su Consejo Consultivo zona sur en 2009-2010, hasta enero de 2010 la calidad de la leche fría que se entrega a las plantas pasteurizadoras en el sur de Sinaloa ha aumentado en 23%.
Según los avances de resultados, este incremento en la calidad de la leche se debe a las buenas prácticas de ordeño que los productores han implementado en sus unidades de producción, como parte de los cursos impartidos por el proyecto Capacitación a productores y técnicos en prácticas de manejo sanitario y ordeño que contribuyan a mejorar la calidad de la leche en ganado bovino.
Los avances del proyecto indican que hasta enero de 2010 el conteo de células ?somáticas? (?células que forman el conjunto de tejidos y órganos de un ser vivo?) se encontraba entre 90 mil y 460 mil células somáticas por mililitro de leche, mientras que en julio de 2008 se cuantificaban de 300 mil a un millón 750 mil por mililitro de leche. Al considerar el nivel más elevado de los rangos anteriores, la diferencia es de 290 mil células somáticas menos.
¿Qué es y para qué sirve el conteo de células somáticas en leche?
El conteo de células somáticas por mililitro de leche es la técnica más confiable de que se dispone por el momento para evaluar indirectamente el estado de salud intramamaria de la vaca, así como para estimar el grado de mastitis que puede tener el hato.
Un alto conteo de células somáticas en la leche de vacas individuales o en el tanque de enfriamiento significa que las bacterias han invadido la ubre de la vaca, y que hay una respuesta de defensa. Las ubres son más sanas cuanto más bajo sea el número de células somáticas. Ver Cuadro 1.
Pérdidas por mastitis
En México se ha estimado que las infecciones intramamarias en la ubre de la vaca (como mastitis) causan mermas en la producción láctea hasta del 30% al año, esto significa que si el promedio es de 2 mil 500 litros de leche de producción por lactancia en el sistema de doble propósito semiintensivo, cada vaca infectada deja de producir entre 750 y mil litros de leche por año, lo que se traduce en alrededor de 4.25 millones de litros por año si se consideran 5 mil 500 vacas con mastitis. Esto arrojaría una pérdida anual de 22.1 millones de pesos.
Aunado a la pérdida de leche se debe tomar en cuenta que el costo promedio anual por tratamiento de mastitis es de mil 200 por vaca, por lo que si 5 mil 500 vacas son tratadas para esta infección el costo de manejo sanitario para esta enfermedad ascendería a 6 millones 600 mil pesos por año.
Pruebas de diagnóstico de mastitis en vacas lecheras
Una gran variedad de pruebas de diagnóstico son rutinariamente usadas para diagnosticar la mastitis y evaluar la calidad de la leche. Para el diagnóstico de mastitis se dispone del Examen físico de la ubre, Prueba California (CMT), Prueba Wisconsin (WT), Determinación de pH, cultivos individuales, cultivos de leche en tanque, anticuerpos por prueba de ELISA (ProStaph), conductividad eléctrica en línea y portátil (Mas-D-Tec) y conteo celular somático.
Para la detección de mastitis subclínica se recomienda la Prueba California, que consiste en vaciar los dos o tres primeros chorros de leche de cada cuarto en una paleta de plástico de cuatro compartimentos, posteriormente se agrega el reactivo en partes iguales y con movimientos circulares se mezclan. Al mezclarse, la reacción podrá ser negativa o positiva en diversos grados: trazas, reacción 1, reacción 2 y reacción 3. El Cuadro 2 muestra la interpretación de resultados característicos de la prueba.
Los resultados de la Prueba California permiten evaluar el estado de salud de la ubre, el manejo e higiene de la ordeña y sirven para implementar medidas correctivas para mantener ubres sanas y obtener leche de mejor calidad sanitaria.
La rutina de ordeño
A continuación se muestra el procedimiento para manejo e higiene del ordeño, con el que se preserva la calidad sanitaria de la leche y se controla la propagación de enfermedades de la ubre.
1. Lavado de la ubre y pezones con solución antiséptica. La ubre y pezones de las vacas se deben lavar con agua y jabón para eliminar residuos de tierra y excreción.
Posteriormente se lavan los pezones y la ubre con agua clorada (a 10 mililitros de cloro al 3% en 15 litros de agua) para desinfectarlos, con el fin de no contaminar la leche al momento del ordeño. Al realizar el lavado de la ubre se aprovecha para efectuar un masaje que estimule la bajada de la leche.
2. Secado de la ubre y pezones. Con el fin de no contaminar la leche con residuos de la solución desinfectante, la ubre y pezones se secan con un lienzo de tela absorbente o con una toalla de papel (se debe emplear una toalla por pezón). Si se utiliza un lienzo, éste deberá lavarse después de ser empleado en cada vaca.
3. Despunte y prueba de fondo oscuro. Para detectar mastitis clínica mediante ordeño manual, se vierten los primeros chorros de leche de cada cuarto en un tazón de fondo oscuro, para observar la presencia de grumos o ?tolondrones?.
En caso de detectarse estas alteraciones, la vaca se debe ordeñar después de todas las vacas sanas, para evitar un contagio.
Después del ordeño, a las vacas afectadas se les debe aplicar un tratamiento antimicrobiano. La leche obtenida de los cuartos enfermos durante el tratamiento y tres días después del término de éste debe desecharse. La leche de los cuartos restantes debe destinarse a la crianza artificial de becerros.
4. Colocación de la unidad de ordeño. Realizada la prueba anterior, se colocan las pezoneras en las tetas de las vacas y se abre la válvula de vacío para realizar el ordeño, esto se debe hacer lo más rápido posible, para aprovechar el estímulo de bajada de leche. Se debe tener especial cuidado en calibrar las pulsaciones de 40 a 60 por minuto, y la presión de vacío de 33 a 35 milímetros o de 12.5 a 13.5 pulgadas de mercurio.
5. Exprimido de la ubre. Cuando se observa que deja de fluir leche por el colector o visor se realiza el exprimido, que consiste en presionar la ubre de arriba hacia abajo para extraer la leche residual y hacer un ordeño profundo, sobre todo en vacas de ordeño lento; con esto se puede prevenir el crecimiento de microorganismos causantes de la mayoría de las mastitis.
6. Retiro de las pezoneras. Cuando cesa el flujo de la leche es el momento oportuno para retirar las pezoneras, suspendiendo el vacío de aire. Un ordeño insuficiente o un sobreordeño son causas que predisponen la mastitis.
7. Desinfección de las pezoneras. Para evitar la transmisión de mastitis, después de ordeñar a una vaca las pezoneras se sumergen en una cubeta con 10 mililitros de yodo o cloro al 3% y 10 litros de agua. Se recomienda cambiar la solución después de haber ordeñado de 12 a 15 vacas.
8. Sellado de las tetas. Consiste en impregnar la punta de los pezones con una solución selladora hecha a base de antisépticos y gel adherente, esto evita que ingresen microorganismos causantes de mastitis por el esfínter abierto.
9. Registro de la producción de leche. Después del ordeño de cada vaca, con la cantidad de leche acumulada en un medidor se prevé la cantidad en kilogramos de leche producida, que se anota en la hoja de registro semanal. Posteriormente, esta información se registra cada mes en las tarjetas individuales de las vacas, para determinar la producción de leche por lactancia.
10. Lavado y desinfección del equipo y sala de ordeño. Al término de cada ordeño debe lavarse y desinfectarse el equipo, para remover residuos de leche y depósitos de grasa en las mangueras, tuberías y medidores. La rutina de lavado y desinfección apropiada es la que se detalla a continuación.
a) Circular agua limpia por toda la tubería del equipo para eliminar residuos de leche.
b) Lavar la tubería del equipo con una mezcla de agua y detergente alcalino, a una temperatura entre 60 y 70 °C.
c) Enjuagar la tubería con agua limpia, a temperatura ambiente.
d) Cada tercer día, pasar por toda la tubería una mezcla de agua y detergente ácido y, posteriormente, enjuagar la tubería con agua limpia, a temperatura ambiente.
e) Los peroles y otros depósitos de leche se deben lavar con detergente alcalino, enjuagar con agua limpia y, posteriormente, con la solución desinfectante.
f) Lavar el área de ordeño con cepillo, detergente de uso doméstico y agua a chorro.
RESULTADOS 2008-2009
Durante 2008-2009, el proyecto Capacitación a productores y técnicos en prácticas de manejo sanitario y ordeño que contribuyan a mejorar la calidad de la leche en ganado bovino arrojó los siguientes resultados.
1. Se capacitó a 186 productores y 40 técnicos en manejo integral de mastitis.
2. La implementación de buenas prácticas de higiene y manejo sanitario integral de mastitis, aunada al monitoreo de células somáticas por mililitro de leche en tanque, así como la realización de la Prueba California para diagnóstico de mastitis subclínica permitieron reducir un rango entre 90 mil y 550 mil células somáticas por mililitro de leche en tanque frío.
3. Se realizó capacitación personalizada de 30 ordeñadores del sistema de producción de leche semiintensivo, lo que permitió mejorar los indicadores de calidad de leche fría que se entrega a las plantas pasteurizadoras.
4. Se determinó que el muestreo de leche en tanque de manera individual, con el Contador de Células Somáticas, fue determinante para tomar medidas de control oportunas de mastitis.
5. Como resultado de la capacitación, se mejoraron las prácticas de manejo en higiene de equipo de ordeño, Prueba California, tratamiento de mastitis con antibióticos, secado de vacas, limpieza de sala de ordeño, desinfección de sala y equipo de ordeño, así como manejo de vacas especiales (con problemas de mastitis).
Con información proporcionada por Juan Esteban Reyes Jiménez, integrante del Instituto Nacional de Investigaciones Forestales, Agrícolas y Pecuarias (INIFAP).
Cuadro 1. ¿Cómo interpretar el conteo de células somáticas y su impacto en la producción de leche?

Cuadro 2. Interpretación de resultados de la Prueba California.

A la venta, folleto sobre elaboración de productos deshidratados de nopal verdura
 Fundación Produce Sinaloa (FPS), A. C., lanza a la venta el folleto Elaboración de productos deshidratados de nopal verdura, con un costo de recuperación de 30 pesos. La publicación se puede adquirir en los módulos de venta de FPS y a través de la página electrónica www.fps.org.mx
Fundación Produce Sinaloa (FPS), A. C., lanza a la venta el folleto Elaboración de productos deshidratados de nopal verdura, con un costo de recuperación de 30 pesos. La publicación se puede adquirir en los módulos de venta de FPS y a través de la página electrónica www.fps.org.mx
El folleto a la venta presenta la metodología para la elaboración de dos productos deshidratados de nopal verdura a través de dos soluciones ?osmóticas? (?de osmosis: proceso mediante el que un disolvente pasa de una solución menos concentrada a otra más concentrada, a través de una membrana semipermeable?): una de 30 °Brix de miel de abeja, y otra de 40 °Brix de azúcar. Los °Brix son una medida alimentaria que mide el total de azúcar disuelto en un líquido.

